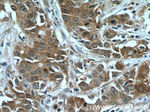
FOXO3A Antibody in Immunohistochemistry (Paraffin) (IHC (P))
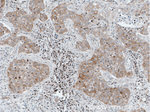
FOXO3A Antibody in Immunohistochemistry (Paraffin) (IHC (P))
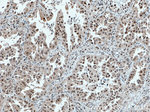
FOXO3A Antibody in Immunohistochemistry (Paraffin) (IHC (P))

Search
Proteintech
FOXO3A Monoclonal Antibody (1F12D11)
{{$productOrderCtrl.translations['antibody.pdp.commerceCard.promotion.promotions']}}
{{$productOrderCtrl.translations['antibody.pdp.commerceCard.promotion.viewpromo']}}
{{$productOrderCtrl.translations['antibody.pdp.commerceCard.promotion.promocode']}}: {{promo.promoCode}} {{promo.promoTitle}} {{promo.promoDescription}}. {{$productOrderCtrl.translations['antibody.pdp.commerceCard.promotion.learnmore']}}
产品信息
66428-1-IG
种属反应
已发表种属
宿主/亚型
分类
类型
克隆号
抗原
偶联物
形式
浓度
规格
纯化类型
保存液
内含物
保存条件
运输条件
产品详细信息
The calculated molecular weight of FOXO3 is 71 kDa, but some experiments using a FOXO3a specific antibody showed the expression of a 90 kDa full-length FOXO3a protein (Full) and a 40 kDa processed FOXO3a product (Short).
Immunogen sequence: SPIMASTEL DEVQDDDAPL SPMLYSSSAS LSPSVSKPCT VELPRLTDMA GTMNLNDGLT ENLMDDLLDN ITLPPSQPSP TGGLMQRSSS FPYTTKGSGL GSPTSSFNST VFGPSSLNSL RQSPMQTIQE NKPATFSSMS HYGNQTLQDL LTSDSLSHSD VMMTQSDPLM SQASTAVSAQ NSRRNVMLRN DPMMSFAAQP NQGSLVNQNL LHHQHQTQGA LGGSRALSNS VSNMGLSESS SLGSAKHQQQ SPVSQSMQTL SDSLSGSSLY STSANLPVMG HEKFPSDLDL DMFNGSLECD MESIIRSELM DADGLDFNFD SLISTQNVVG LNVGNFTGAK QASSQSWVPG (325-673 aa encoded by BC021224)
靶标信息
USP48 is a protein containing domains that associate it with the peptidase family C19, also known as family 2 of ubiquitin carboxyl-terminal hydrolases. Family members function as deubiquitinating enzymes, recognizing and hydrolyzing the peptide bond at the C-terminal glycine of ubiquitin. Enzymes in peptidase family C19 are involved in the processing of poly-ubiquitin precursors as well as that of ubiquitinated proteins.
仅用于科研。不用于诊断过程。未经明确授权不得转售。
生物信息学
蛋白别名: AF6q21 protein; forkhead box O3A; Forkhead box protein O3; forkhead homolog (rhabdomyosarcoma) like 1; Forkhead in rhabdomyosarcoma-like 1; forkhead protein FKHR2; forkhead, Drosophila, homolog of, in rhabdomyosarcoma-like 1; FOXO3A-; unnamed protein product
基因别名: 1110048B16Rik; 2010203A17Rik; AF6q21; C76856; Fkhr2; FKHRL1; FKHRL1P2; FOXO2; FOXO3; FOXO3A
UniProt ID: (Human) O43524, (Mouse) Q9WVH4
Entrez Gene ID: (Human) 2309, (Mouse) 56484, (Rat) 294515